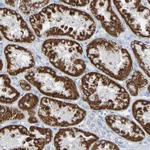
ACMSD Antibody in Immunohistochemistry (Paraffin) (IHC (P))
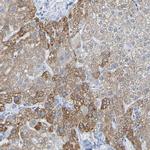
ACMSD Antibody in Immunohistochemistry (Paraffin) (IHC (P))

Search
Invitrogen
ACMSD Polyclonal Antibody
{{$productOrderCtrl.translations['antibody.pdp.commerceCard.promotion.promotions']}}
{{$productOrderCtrl.translations['antibody.pdp.commerceCard.promotion.viewpromo']}}
{{$productOrderCtrl.translations['antibody.pdp.commerceCard.promotion.promocode']}}: {{promo.promoCode}} {{promo.promoTitle}} {{promo.promoDescription}}. {{$productOrderCtrl.translations['antibody.pdp.commerceCard.promotion.learnmore']}}
产品信息
PA5-82420
种属反应
宿主/亚型
分类
类型
抗原
偶联物
形式
浓度
规格
纯化类型
保存液
内含物
保存条件
运输条件
RRID
产品详细信息
Immunogen sequence: KGEAKLLKDG KVFRVVRENC WDPEVRIREM DQKGVTVQAL STVPVMFSYW AKPEDTLNLC QLLNNDLAST VVSYPRRFVG LGTLPMQAPE LAVKEMERCV KELGFPGVQI GTHVNEWDLN AQELFPVYAA AERLKCSLFV HPW
Highest antigen sequence indentity to the following orthologs: Mouse - 84%, Rat - 72%.
靶标信息
The neuronal excitotoxin quinolinate is an intermediate in the de novo synthesis pathway of NAD from tryptophan, and has been implicated in the pathogenesis of several neurodegenerative disorders. Quinolinate is derived from alpha-amino-beta-carboxy-muconate-epsilon-semialdehyde (ACMS). ACMSD (ACMS decarboxylase; EC 4.1.1.45) can divert ACMS to a benign catabolite and thus prevent the accumulation of quinolinate from ACMS.[supplied by OMIM, Oct 2004]
仅用于科研。不用于诊断过程。未经明确授权不得转售。
篇参考文献 (0)
生物信息学
蛋白别名: 2-amino-3-carboxymuconate-6-semialdehyde decarboxylase; Picolinate carboxylase; unnamed protein product
基因别名: ACMSD
UniProt ID: (Human) Q8TDX5
Entrez Gene ID: (Human) 130013